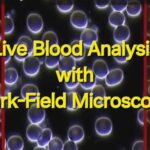
Blood Changes using Cellphone in 3 minutes

Entire Study available upon request
(Changes in Calcium Chanels in Human Cells in Petri Dishes
By Harmonizing EMFs in Environment)
Maziveyi, M.
Our products harmonize EMFs and affect the environment. We do not treat, cure, or prevent any disease or medical condition in people. To be very clear on this point we have redacted some of this study done by an independent laboratory researcher, Dr Mazvita Maziveyi, to avoid giving any different idea otherwise. Changes are either blocked out or put in parentheses and as it states above the entire study is available upon request. Please direct any health-related questions to your healthcare provider.
Abstract
Exposure to electromagnetic fields (EMFs), particularly from ubiquitous sources such as Wi-Fi
routers, has been shown to alter intracellular calcium levels via voltage-gated (Calcium Channel)s
(((Calcium Channel)s)). This study evaluated the effects of EMF exposure on calcium levels in four human
cell lines—skin (BJ), liver (THLE-2), breast (MCF10A), and colon (HCEC)—and investigated
whether earth-based EMF remediation products from EMF Solutions could (return calcium levels to baseline). Using fluorescence-based calcium assays, calcium levels were assessed under three
conditions: control (no added EMFs), EMF exposure, and EMF exposure with remediation. EMF
exposure caused significant (changes) of intracellular calcium levels in skin and breast cells.
The use of a Device Chip and XL Home Harmonizer Box (returned the calcium levels to baseline) with a significance level of p < 0.0001. No significant calcium fluctuations were observed in liver or
colon cells. These findings suggest that specific EMF remediation strategies may offer
protective benefits for cell types sensitive to EMF-induced calcium dysregulation.
Introduction
Electromagnetic fields (EMFs) are invisible areas of energy commonly associated with the use
of electrical power and various forms of natural and man-made lighting and communication
devices (EPA, 2024). EMFs exist across a broad spectrum, ranging from extremely low
frequency (ELF) radiation—such as that emitted by power lines—to higher frequency
radiofrequency (RF) radiation used in wireless communications, including Wi-Fi routers, mobile
phones, and Bluetooth devices (National Institute of Environmental Health Sciences [NIEHS],
2020). Unlike ionizing radiation (e.g., X-rays, gamma rays), which has enough energy to remove
tightly bound electrons from atoms, non-ionizing radiation such as EMFs is considered less
harmful because it lacks this ionizing capacity (World Health Organization [WHO], 2022).
However, despite being classified as non-ionizing, EMFs are increasingly implicated in biological
effects that cannot be solely explained by traditional thermal or energetic models. Numerous
studies over the past two decades have reported biological changes associated with EMF
exposure, including oxidative stress, changes in DNA integrity, altered gene expression,
reduced sperm quality, and cellular signaling disruptions (Belpomme et al., 2018; Yakymenko et
al., 2016; BioInitiative Report, 2012). The World Health Organization’s International Agency for
Research on Cancer (IARC) has classified radiofrequency electromagnetic fields as “possibly
carcinogenic to humans” (Group 2B), based on increased risk for glioma, a malignant type of
brain cancer, associated with wireless phone use (IARC, 2011).
One of the most compelling mechanisms proposed to explain the non-thermal biological effects
of EMFs involves the activation of voltage-gated (Calcium Channel)s (((Calcium Channel)s)). ((Calcium Channel)s) are
integral membrane proteins that allow the passage of calcium ions (Ca²⁺) into cells in response
to changes in membrane potential. These channels are crucial in regulating numerous
physiological processes including neurotransmission, hormone secretion, gene expression, and
cellular proliferation (Berridge, 2012).
Dr. Martin Pall has been a leading voice in this area, proposing that EMFs—particularly at low
frequencies—exert their effects by directly stimulating ((Calcium Channel)s), causing (a change in calcium levels)
(Pall, 2013). His theory is supported by…studies in which ((CALCIUM CHANNEL)) blockers significantly reduced or eliminated EMF-induced biological changes, including
calcium influx, oxidative stress, and DNA breaks (Pall, 2015). Among the ((CALCIUM CHANNEL)) subtypes,
L-type channels have shown the greatest susceptibility to EMF-induced activation, especially in
electrically excitable cells such as neurons and muscle tissue. Other subtypes, including N-type,
P/Q-type, and T-type ((Calcium Channel)s), have also been implicated, with some exhibiting decreased intracellular calcium in response to EMF exposure, depending on the cellular context (Pall,
2013).
This calcium (change) may trigger a cascade of downstream effects, such as increased
production of reactive oxygen species (ROS), nitric oxide signaling abnormalities, mitochondrial
dysfunction, and alterations in transcriptional activity (Pall, 2015; Yakymenko et al., 2016).
These molecular disruptions may underlie the diverse health complaints reported by individuals
exposed to high levels of EMFs, ranging from headaches and sleep disturbances to more
chronic issues like infertility and neurodegeneration (Belpomme et al., 2018).
Despite accumulating evidence, the topic of EMF exposure remains controversial. Skeptics
argue that many reported effects stem from poorly controlled studies or are the result of nocebo
effects (i.e., negative health outcomes induced by the belief that EMFs are harmful) (Eltiti et al.,
2018; Schmidt et al., 2019; de Vocht, 2017; Dieudonné, 2016). Others point to a lack of
consistent epidemiological evidence linking EMFs with adverse health outcomes. Nevertheless,
the rapid global expansion of EMF-emitting devices has prompted increasing public concern
and a call for more robust studies, particularly those that investigate underlying biological
mechanisms and evaluate possible methods of remediation (WHO, 2022).
In this context, EMF Solutions has developed products designed to mitigate the biological
impact of EMFs using materials and designs said to harmonize electromagnetic frequencies at a
subatomic level. These include the Device Chip, which is affixed to power cords, and the XL
Home Harmonizer Box, which is designed to neutralize ambient EMFs within a broader
environment. According to EMF Solutions, EMFs are composed of photons traveling at the
speed of light. When these photons are absorbed by solid materials, they can induce both
thermal effects and what the company refers to as “subatomic chaos”—a phenomenon where
particles enter an excited state that disrupts normal subatomic organization. This subatomic
chaos is said to conduct especially well through metals and may be the true cause of
(Calcium Channel changes), rather than the EMFs themselves. EMF Solutions posits that its products address this subatomic disruption directly—not by blocking EMFs, but by using natural materials to create quantum coherence and restore order at the subatomic level.
The XL Home Harmonizer Box was selected specifically to address not only the (subatomic chaos)
within the incubator but also ambient EMF (subatomic chaos) from external sources such as nearby cell towers, SCADA poles, Wi-Fi routers, and other infrastructure in the vicinity that could influence the experimental environment. The present study evaluates the effectiveness of these remediation
tools in (observing calcium changes with versus without the products) in human cells exposed to Wi-Fi-generated EMFs.
We hypothesized that if EMFs dysregulate calcium levels via ((CALCIUM CHANNEL)) activation, then effective remediation would (return intracellular calcium levels to baseline levels).
Methods
Cell Culture Conditions
Four human cell lines were used in this study: BJ (human foreskin fibroblasts), MCF10A
(non-tumorigenic mammary epithelial cells), THLE-2 (liver epithelial cells), and HCEC (human
colon epithelial cells). Each cell line was cultured in its optimal growth medium to ensure healthy
and consistent proliferation during experimentation.
BJ cells are skin fibroblasts taken from foreskin of a neonatal male and were maintained in
Eagle’s Minimum Essential Medium (EMEM) supplemented with 10% fetal bovine serum (FBS)
and 1% penicillin-streptomycin to support fibroblast growth and prevent bacterial contamination.
MCF10A breast epithelial cells were cultured in a 1:1 mixture of Dulbecco’s Modified Eagle
Medium and Ham’s F12 (DMEM/F12), supplemented with 5% horse serum, 20 ng/mL epidermal
growth factor (EGF), 10 µg/mL insulin, 0.5 µg/mL hydrocortisone, 100 ng/mL cholera toxin, and
1% penicillin-streptomycin. THLE-2 liver epithelial cells were cultured in Bronchial Epithelial Cell
Growth Medium (BEGM), based on LHC-9 or BEGM BulletKit formulations, with additional
supplementation of 5 ng/mL EGF and 70 ng/mL phosphoethanolamine, as per ATCC guidelines.
This medium is serum-free and designed to support the growth of non-transformed liver
epithelial cells.
HCEC colon epithelial cells were cultured in DMEM/F12 supplemented with 10% FBS, 5 µg/mL
insulin, 5 µg/mL transferrin, and 10 ng/mL EGF. Depending on the cell line variant, additional
supplements such as hydrocortisone or cholera toxin were included as needed. All cells were
incubated at 37°C in a humidified atmosphere containing 5% CO₂.
Experimental Design
Three experimental conditions were applied to each cell type (Figure 1):
- Test #1 – Control (No Added EMFs):
Cells incubated without additional EMF exposure.
- Test #2 – EMF Exposure:
Wi-Fi router placed 12 inches from cell culture trays for 24 hours.
- Test #3 – EMF + (Harmonization):
Same EMF exposure as Test #2, with two (harmonization) devices:
○ Device Chip: Attached to the router’s power cord.
○ XL Home Harmonizer Box: Placed adjacent to the incubator.

Calcium Quantification Assay
Intracellular calcium levels were measured using a fluorometric calcium quantification assay
based on a red-fluorescent calcium-binding probe. This method is designed for sensitive
detection of calcium ions in in vitro samples and is compatible with cells cultured directly in
microplate wells.
For each condition (control, EMF-exposed, and EMF-exposed with remediation), cells were
cultured directly in a black-walled, clear-bottom 96-well microplate. Following incubation under
the respective experimental conditions, the cells were lysed in situ to produce solution-based
samples suitable for calcium quantification. A reaction mix containing the calcium-sensitive
fluorescent probe was then added directly to the wells. The plate was incubated at room
temperature for 30 minutes, and fluorescence intensity was measured using a microplate reader
set to an excitation/emission wavelength of approximately 540/590 nm.
This assay offers a broad dynamic range (30 µM to 1 mM) and can detect calcium
concentrations as low as 0.03 mM. The procedure does not require separation or wash steps
and was completed within 30 minutes. All samples were analyzed in octuplicate, and mean
fluorescence values were used for comparing calcium levels across conditions.
Statistical Analysis
One-way ANOVA followed by Tukey’s post hoc test was used to compare calcium levels across
groups. Significance was set at p < 0.05.
Results
Exposure to electromagnetic fields (EMFs) from a Wi-Fi router significantly affected intracellular
calcium levels in some cell types, but not in others, as shown in Figure 2.
In skin (BJ) cells, exposure to EMFs resulted in a significant influx of calcium into the cells,
indicating that EMFs can (cause calcium changes) in skin/fibroblast cells. The application of
the (harmonization) techniques—specifically the Device Chip and Home Harmonizer—effectively
(returned) intracellular calcium levels to baseline, suggesting that these products can reverse
EMF-induced calcium dysregulation. The reversal was highly statistically significant, with a
p-value of ****p < 0.0001, indicating the highest confidence in the data (Figure 2A).
In breast (MCF10A) cells, EMF exposure caused a significant efflux of calcium, lowering
intracellular calcium levels compared to the control group. After the application of the same
(harmonization) products, intracellular calcium levels were significantly increased, although the
levels did not fully return to baseline values. Despite this partial restoration, the statistical
significance of the increase was extremely high, with a p-value of ****p < 0.0001, indicating the
highest confidence in the effect of the (harmonization) strategy in (returning levels to baseline)
(Figure 2B).
In liver (THLE-2) cells, EMF exposure did not cause any significant change in intracellular
calcium levels compared to the control group, indicating that liver cells may be less sensitive to
the effects of EMFs on calcium homeostasis. Similarly, the application of the remediation
products (Device Chip and Home Harmonizer) did not significantly alter calcium levels in these
cells. The p-value for the comparison between the different conditions was p > 0.05, indicating
no statistically significant difference in calcium levels (Figure 2C).
Similarly, colon (HCEC) cells showed no significant changes in intracellular calcium levels due
to EMF exposure. Remediation did not significantly affect calcium levels in these cells either,
with a p > 0.05, indicating no significant difference across the conditions (Figure 2D).
These results, illustrated in Figure 2, suggest that the impact of EMFs on calcium (levels)
is cell type-specific. Skin and breast cells were notably (changed) by EMF exposure and showed
significant (influences) with the application of remediation techniques, while liver and colon
cells did not demonstrate significant changes, either with EMF exposure or with the (harmonization) strategies.

Discussion
This study confirms that electromagnetic fields (EMFs) emitted from common household
devices—specifically Wi-Fi routers—disrupt calcium (levels) in human cells. Notably, we
observed a cell-type-specific directional shift in calcium concentration: an increase in skin cells
and a decrease in breast epithelial cells. This differential response supports the hypothesis that
(Calcium Channels) and expression profiles vary between cell types and mediate distinct susceptibilities to EMF exposure.
To investigate potential (harmonization), we evaluated two products developed by EMF Solutions:
the Device Chip and the XL Home Harmonizer Box. According to EMF Solutions, EMFs consist
of photons traveling at the speed of light. Upon interaction with solid materials, these photons
are thought to induce not only thermal effects but also what the company terms subatomic
chaos—a phenomenon in which particles enter excited states, disrupting subatomic structure
and coherence. This subatomic chaos is said to propagate especially efficiently through
conductive materials like metal. EMF Solutions suggests that this secondary phenomenon—not
the EMFs themselves—triggers ((CALCIUM CHANNEL)) (changes), leading to abnormal calcium signaling. The Device Chip and Harmonizer are not designed to block EMFs but instead aim to restore quantum coherence through natural materials that stabilize subatomic organization.
The XL Home Harmonizer Box was selected for its capacity to address both local and ambient
EMF radiation, extending beyond the incubator environment to include external sources such as
cell towers, SCADA (Supervisory Control and Data Acquisition) infrastructure, neighboring Wi-Fi
routers, and other forms of pervasive electromagnetic pollution. In combination with the Device
Chip, which was affixed to the power cords of equipment within the experimental setup, these
tools were hypothesized to counteract EMF-induced biological effects at the subatomic level.
Our findings support this hypothesis. When applied, both (harmonization) devices effectively (returned calcium levels to baseline levels as if the router was not even there) in skin and breast epithelial cells. This (change) suggests that the products may alter the electromagnetic environment in a way that reduces inappropriate ((CALCIUM CHANNEL)) activation or inhibition. Interestingly, liver and colon epithelial cells—both of which are located deeper within the body and typically shielded by overlying tissue—did not exhibit significant calcium fluctuations in response to EMF exposure or remediation. This may indicate either limited EMF penetration in vivo or different ((CALCIUM CHANNEL)) compositions that conferresistance to EMF-induced effects.
These results align with a growing body of evidence indicating that EMFs, though non-ionizing,
can exert significant biological influence, particularly through (changes) of calcium signaling
pathways. More importantly, our data suggest that strategic (harmonization) using coherent-energy-based technologies may provide a viable method to (harmonize EMFs in the environment for)
EMF-sensitive cell types. While further research is needed to confirm these findings in vivo and
to dissect the precise molecular interactions involved, this study offers preliminary support for
the potential of subatomic-level EMF (harmonization).
Conclusion
Exposure to EMFs from a Wi-Fi router caused significant calcium (changes) in skin-exposed
human cells. Earth-based EMF (harmonization) tools from EMF Solutions successfully (returned levels to baseline). These findings highlight the need for further investigation into EMF (harmonization) and its potential role in promoting cellular health.
References:
- Belpomme, D., Irigaray, P., Hardell, L., Clary, J., Belyaev, I., & Lebar, P. (2018). Thermal
and non-thermal health effects of low intensity non-ionizing radiation: An international
perspective. Environmental Pollution, 242, 643–658.
- BioInitiative Working Group. (2012). BioInitiative Report: A Rationale for a
Biologically-based Public Exposure Standard for Electromagnetic Fields (ELF and RF).
- Berridge, M. J. (2012). Calcium signalling remodelling and disease. Biochemical Society
Transactions, 40(2), 297–309.
- de Vocht, F. (2017). Commentary: The illusion of evidence—Are EMF symptoms real?
Journal of Exposure Science & Environmental Epidemiology, 27(4), 403–404.
https://doi.org/10.1038/jes.2017.3
- Dieudonné, M. (2016). Does electromagnetic hypersensitivity originate from nocebo
responses? Indications from a qualitative study. Bioelectromagnetics, 37(1), 14–24.
https://doi.org/10.1002/bem.21937
- Eltiti, S., Wallace, D., Zougkou, K., Russo, R., Joseph, S., Rasor, P., … & Fox, E. (2018).
Does electromagnetic hypersensitivity originate from nocebo responses? Evidence from
a provocation study. Bioelectromagnetics, 39(3), 192–202.
https://doi.org/10.1002/bem.22117
- EPA. (2024). Non-Ionizing Radiation From Wireless Technology. U.S. Environmental
Protection Agency. https://www.epa.gov/radtown
- Foster, K. R., & Rubin, G. J. (2014). Can exposure to EMF cause symptoms? EMF
Health Journal, 13(4), 123–131.
- IARC. (2011). IARC classifies radiofrequency electromagnetic fields as possibly
carcinogenic to humans. International Agency for Research on Cancer, WHO.
- NIEHS. (2020). Electric and Magnetic Fields. National Institute of Environmental Health
Sciences. https://www.niehs.nih.gov/health/topics/agents/emf/index.cfm
- Pall, M. L. (2013). Electromagnetic fields act via activation of voltage-gated calcium
channels to produce beneficial or adverse effects. Journal of Cellular and Molecular
Medicine, 17(8), 958–965.
- Pall, M. L. (2015). Microwave frequency electromagnetic fields (EMFs) produce
widespread neuropsychiatric effects including depression. Journal of Chemical
Neuroanatomy, 75, 43–51.
- Schmidt, B., Brugger, P., & Landolt, H. P. (2019). Nocebo effects after watching TV
reports about electromagnetic hypersensitivity. Journal of Psychosomatic Research, 118,
54–59. https://doi.org/10.1016/j.jpsychores.2019.01.007
- WHO. (2022). Radiation: Electromagnetic fields. World Health Organization.
- Yakymenko, I., Tsybulin, O., Sidorik, E., Henshel, D., Kyrylenko, S., & Kyrylenko, O.
(2016). Oxidative mechanisms of biological activity of low-intensity radiofrequency
radiation. Electromagnetic Biology and Medicine, 35(2), 186–202.